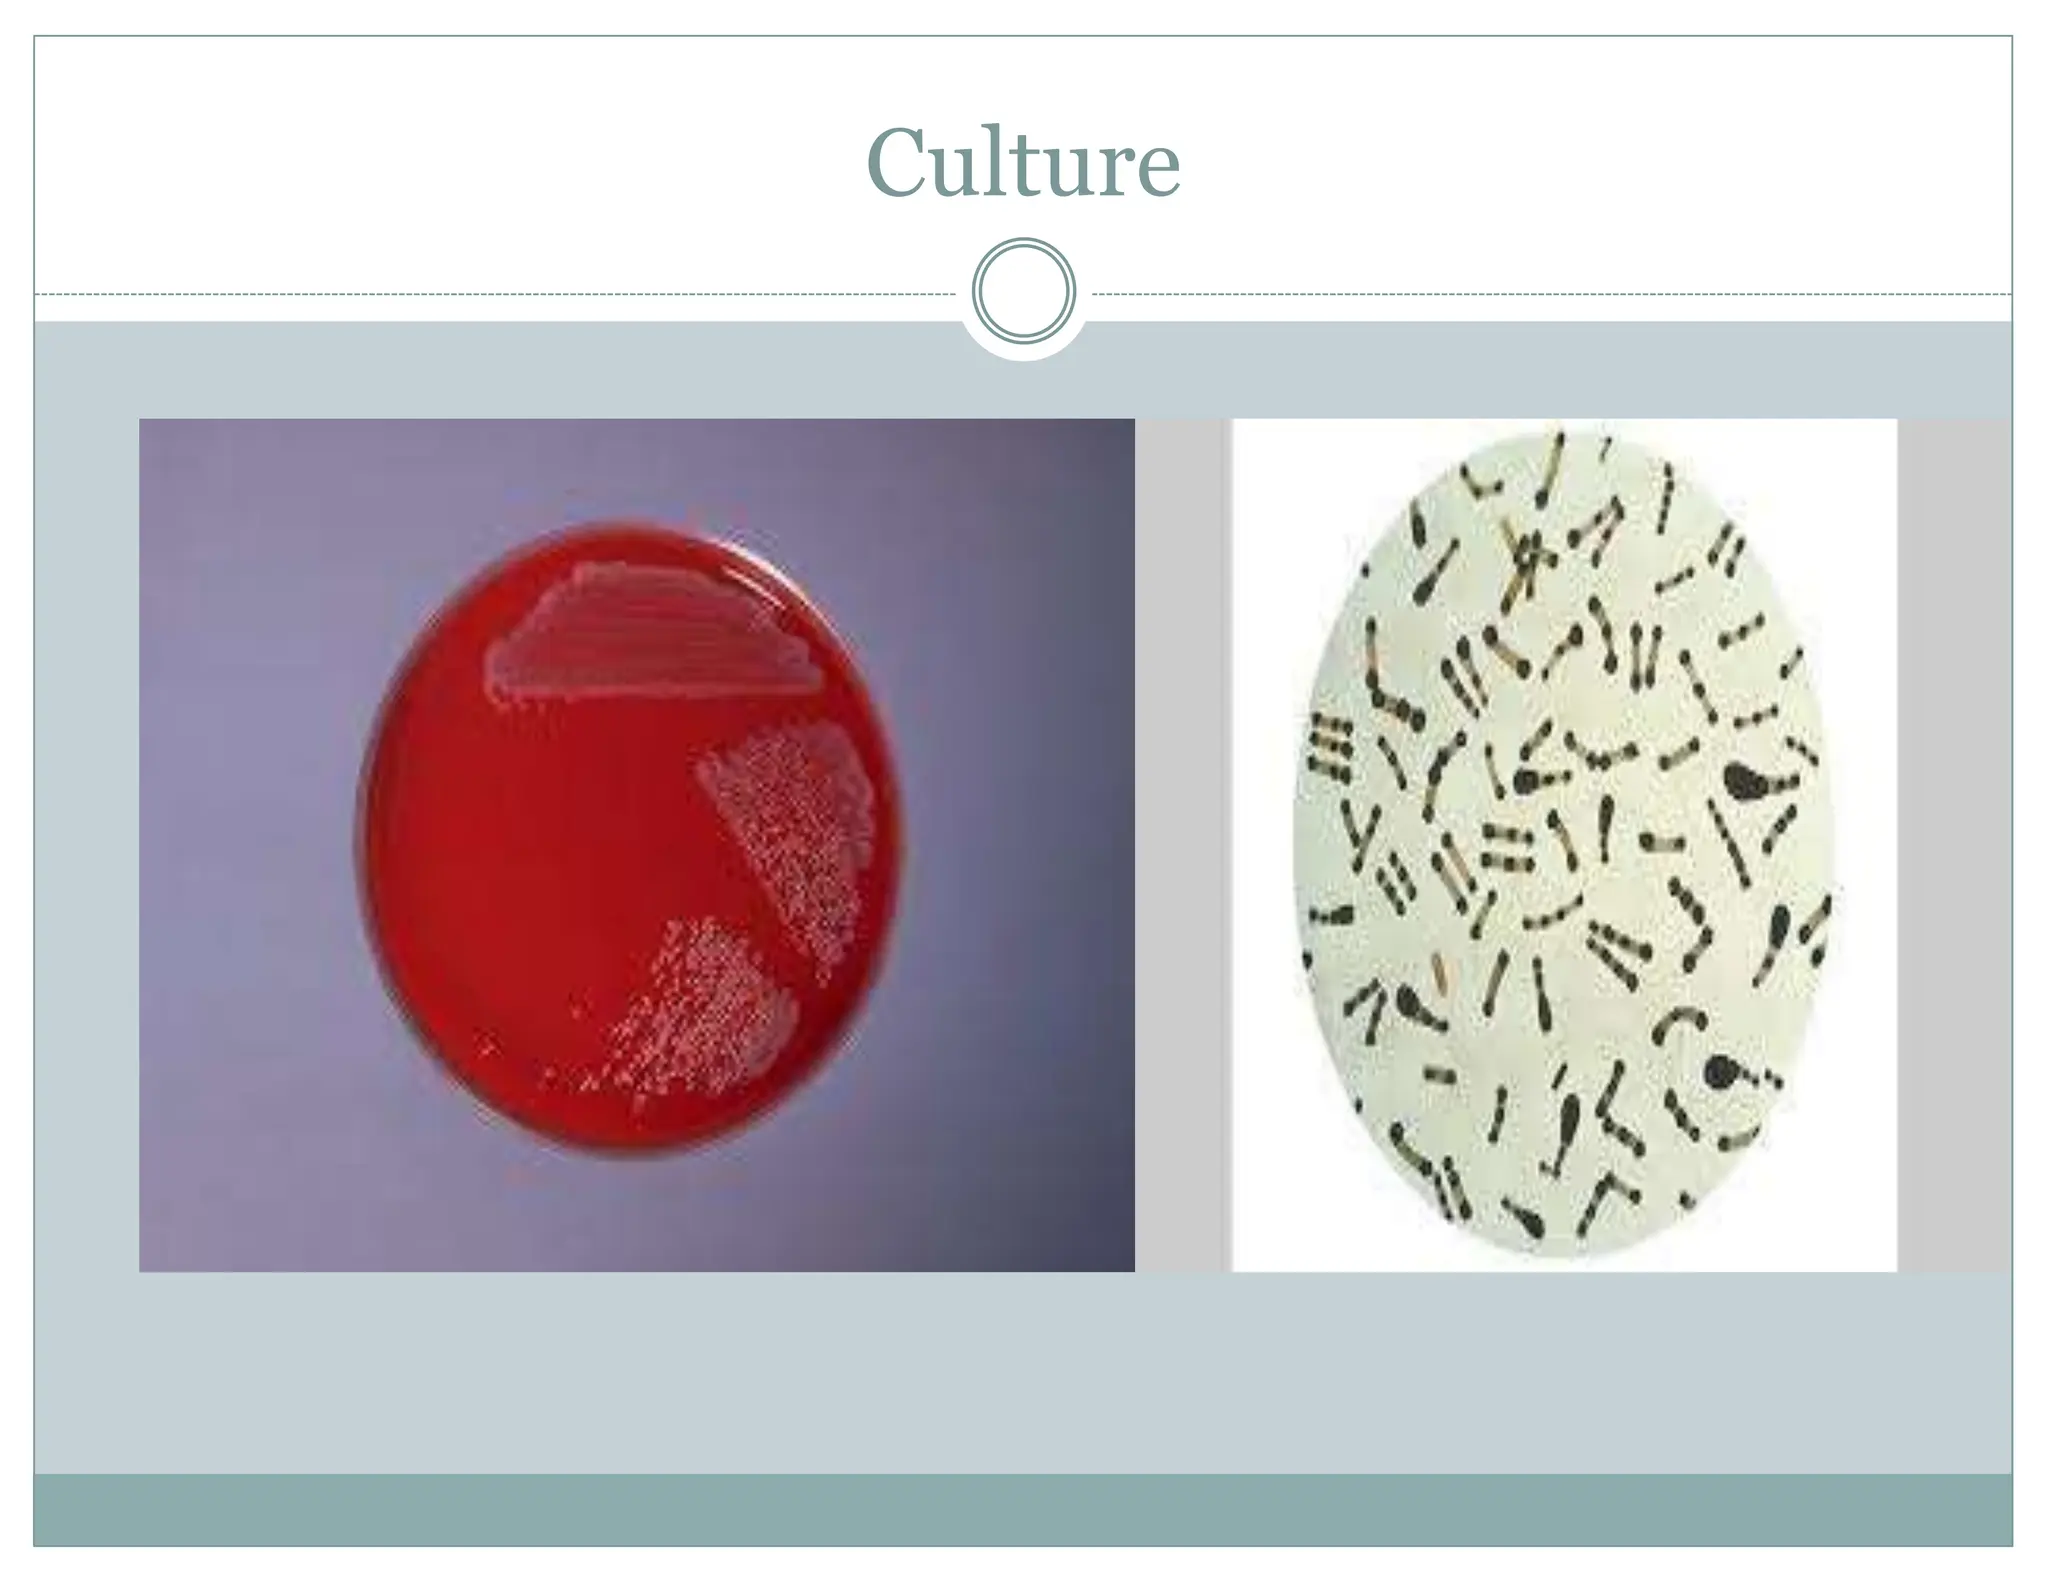
Culture

Diphtheria is caused by the bacterium Corynebacterium diphtheriae, primarily transmitted through human carriers and characterized by respiratory or skin-related symptoms. Diagnosis involves culture and specific staining techniques, with treatment typically requiring penicillin or erythromycin. Vaccination with diphtheria toxoid is crucial for prevention, given to children at specified intervals, with subsequent boosters into adolescence.